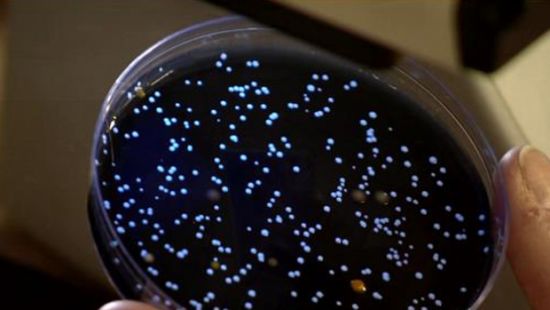
卫生局接获一例军团菌病报告

军团菌图片

嗜肺军团菌
图片尺寸268x214嗜肺性军团菌的细菌
图片尺寸1200x800
早晨起来不放水 喝下军团菌
图片尺寸2048x1152军团菌
图片尺寸1200x783
嗜肺军团菌电镜画面
图片尺寸640x408
有没有做过嗜肺军团菌的朋友,求bcye上嗜肺军团菌图片
图片尺寸1944x2592
【可怕的军团菌是什么?】
图片尺寸1017x1357嗜肺性军团菌的细菌
图片尺寸1200x800
嗜肺军团菌照片
图片尺寸533x300
军团菌肺炎的临床表现
图片尺寸419x273
环境与健康夏日将至要警惕藏在身边的隐形杀手军团菌
图片尺寸294x390
美国多地出现致命军团菌:死亡率比新冠肺炎高得多
图片尺寸658x371
军团菌-医学检验图库
图片尺寸420x309
军团菌病ppt课件
图片尺寸800x600
军团菌病病原嗜肺军团菌
图片尺寸700x394
卫生局接获一例军团菌病报告
图片尺寸550x310
军团菌显微镜下形态.jpg
图片尺寸500x301嗜肺性军团菌的细菌
图片尺寸1200x800美国又发现的军团菌是新细菌已发现44年可致命并非无药可治
图片尺寸641x360
军团菌病
图片尺寸393x295